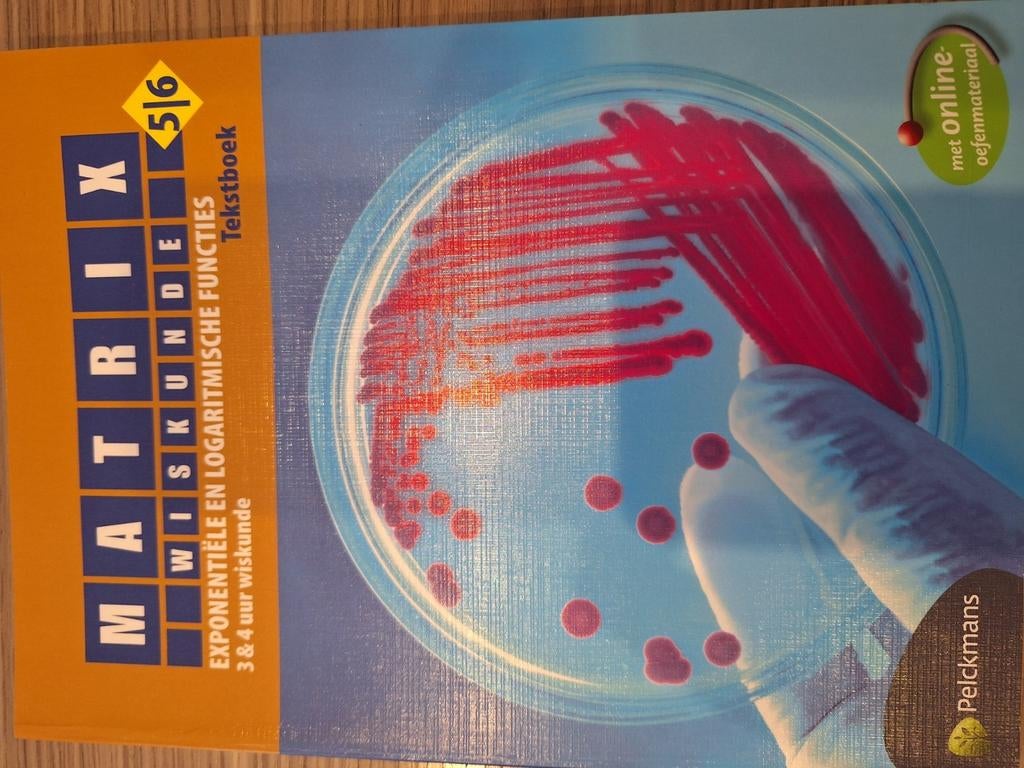
MATRIX WISKUNDE EXPONENTIELE EN LOGARITMISCHR FUNCTIES 3&4 T, Enlèvement, Comme neuf, Néerlandais

② Matériel et Livres de Mathématiques sur les Matrices | 2ememain | Page 3
Explorez une sélection de livres de mathématiques sur les matrices. Apprenez des concepts clés et applications des matrices dans divers domaines académiques. | page 3
Affiner les résultats
Prix
€
€
Offert depuis
- Matrix Wiskunde 5/6 Financiële algebra Leerwerkboek (incl.Boekenbalie maakt van tweedehands jouw eerste keuze. Met een trustscore van 4,8 (excellent) en 30 dagen retour garantie maken we dat iedere dag waar. Bestel direct op onze website! Titel: matrix wiskuVerzenden
€ 14,20
4 avr. 24Pub au topBoekenBalieToute la Belgique - Matrix Wiskunde 5/6 Grafisch onderzoek - Veeltermfuncties 3Korting: nu van 12 euro, voor 9.00 Euro. Boekenbalie maakt van tweedehands jouw eerste keuze. Met een trustscore van 4,8 (excellent) en 30 dagen retour garantie maken we dat iedere dag waar. Bestel diVerzenden
€ 12,00
4 avr. 24Pub au topBoekenBalieToute la Belgique - Matrix Wiskunde 4 Telproblemen & kansrekenen - Rijen 4 & 5Korting: nu van 27.5 Euro, voor 20.63 Euro. Boekenbalie maakt van tweedehands jouw eerste keuze. Met een trustscore van 4,8 (excellent) en 30 dagen retour garantie maken we dat iedere dag waar. BestelVerzenden
€ 27,50
4 avr. 24Pub au topBoekenBalieToute la Belgique - WISKUNDE MATRIX 5H 3ASO LEERWERKBOEK A/BA= logica/getallen/algebra/functies isbn 9789464010862 b= meetkunde /statistiek isbn 9789464011319 in perfecte nieuwstaat 0493/606658Neuf Enlèvement ou Envoi
€ 40,00
24 nov. 23marc schatsSint-Truiden - Wiskundeboek meetkunde statistiekIsbn 978-94-6310-806-5. Matrix wiskunde meetkunde statistiek 3. 3Uur leerwerkboekbNeuf Enlèvement ou Envoi
€ 14,00
22 août 24GeertSint-Maria-Lierde - Matrix Wiskunde 2 (ENKEL het Vademecum)Taal: nederlands; vlaams aantal pagina's: 83 het bevindt zich in volledige nieuwstaat!Enlèvement
€ 3,00
7 déc. 23De Winter ChrisAartselaar - Matrix 2 Xaverius ASOAso 1ste graad. Verzenden via bpost kan mits bijbetaling, ophalen te borgerhout uiteraard ook.Utilisé Enlèvement ou Envoi
€ 2,00
10 nov. 25ChrisBorgerhout - Matrix wiskunde 1 en 2 1,5€/boekHeel erg mooie staat 1,5 euro per boek af te halen te hoboken verzending is ook mogelijkComme neuf Enlèvement ou Envoi
€ 1,50
17 sept. 25gitteverschuerenHoboken - Wiskunde Matrix 3.5 leerwerkboek B meetkunde statistiekHoofstukken 5 vectoren en 6 anaytische meetkunde (p 323 tot 446) zijn er niet bij!! Voor de rest ongebruiktEnlèvement ou Envoi
€ 12,00
10 janv. 26karimHerent - Leerboek Wiskunde Matrix 6 Uitgebreide statistiekIsbn-nummer : 978 94 6337 901 4 vraagprijs : € 13. (Nieuwprijs € 18) boek nog in zeer goede staat. Geen aantekeningen. Contactgegevens : alex van rentergem. Gsm 0487 33 18 41 mail : alexenfrComme neuf Enlèvement
€ 13,00
30 juin 25Alex Van RentergemEvergem - Matrix Wiskunde 2 Correctiesleutel Pelckmans 2013Auteur: lief van duffel, christof berghmans, frieda de lannoy, fabienne duelen, annick jehaes, daisy peelmans, sonja rucqoij, andré snijers uitgever: pelckmans datum: 2013 (isbn 978 90 289 5747 3) kafUtilisé Envoi
Faire une offre
28 nov. 25Citro1Gent - Leerboek wiskunde : Matrix 6 Analyse deel 2Isbn-nummer : 978 94 6337 900 7 vraagprijs : € 13. (Nieuwprijs € 18) boek nog in zeer goede staat. Geen aantekeningen. Contactgegevens : alex van rentergem. Gsm 0487 33 18 41 mail : alexenfrComme neuf Enlèvement
€ 13,00
30 juin 25Alex Van RentergemEvergem - Matrix wiskunde 4 - 5 uur - editie 2024 - leerwerkboeken A+BVolledig nieuw en ongebruikt! Leerwerkboek a en leerwerkboek b nieuwe editie voor september 2024! Prijs = 19,5 euro per leerwerkboekNeuf Enlèvement ou Envoi
€ 19,50
24 juil. 24TKTorhout - Boeken wiskunde 'Matrix' voor derde graad secundairDeze tekstboeken en leerwerkboeken zijn gepubliceerd door uitgeverij pelckmans in 2014 en 2015. Tekstboek voor 4/5/6: complexe getallen a tekstboek voor 5/6: complexe getallen b (6u-8u wiskunde) teksNeuf Enlèvement
Voir description
15 juil. 24GreetNeerpelt - Boeken wiskunde 'Matrix' voor 3 en 4 secundairDeze boeken zijn uitgegeven door de uitgeverij pelckmans in 2012 en 2013. Leerwerkboek voor 3/4: vergelijking van een rechte - functies (voor lln met 3u wiskunde per week) leerwerkboek voor 3/4: bescNeuf Enlèvement
Voir description
15 juil. 24GreetNeerpelt - Matrix WiskundeTaal: nederlands; vlaamsComme neuf Enlèvement ou Envoi
€ 5,00
5 oct. 23Tessy DemesmaekerOudenaarde+Deel OoikeMatrix WiskundeEnlèvement ou Envoi Comme neufTaal: nederlands; vlaamsOudenaarde+Deel Ooike5 oct. 23 - Matrix wiskunde leerwerkboek ANieuw aangekocht tgv vives-academiejaar 1e bachelor secundair onderwijs 2024-2025 (nieuwprijs 27,50 euro)Comme neuf Enlèvement
€ 20,00
7 févr. 25Wim SoenensIngelmunster - OPLOSSINGEN B MATRIX WISKUNDE 5H 3 ASOHandleiding b meetkunde /statistiek 5h 3aso met alle oplossingen nooit gebruikt losgescheurd isbn 9789464012484 versie 2023/2024 0493/606658 (nieuw 50 euro)Neuf Enlèvement ou Envoi
€ 25,00
13 févr. 26marc schatsSint-Truiden